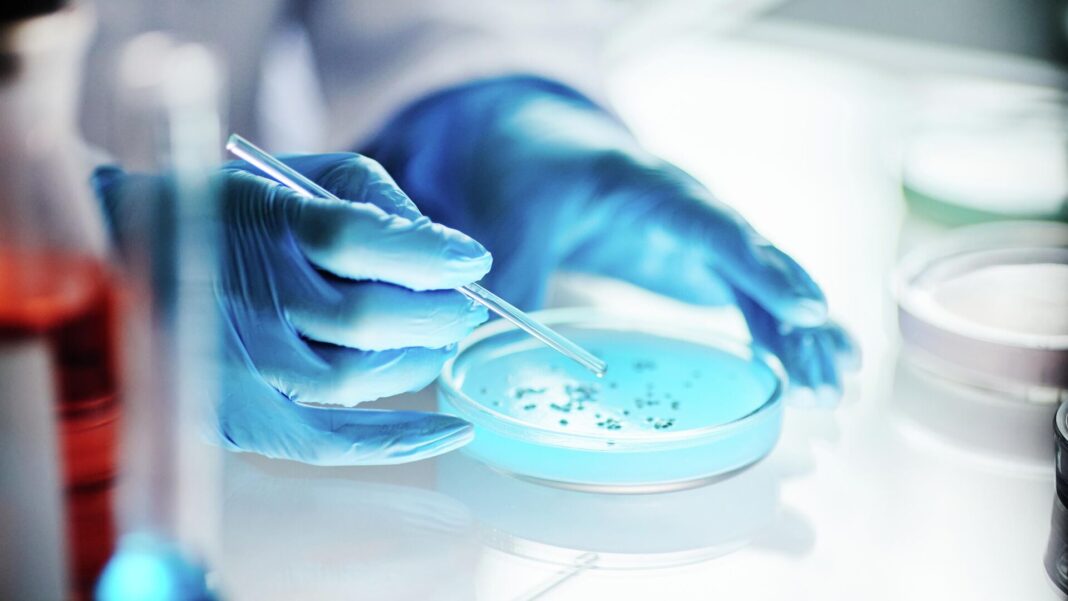

МОСКВА, 18 авг. Значительно повысить эффективность выработки электричества «живыми батарейками» из микробов и растений смогли ученые ТулГУ в составе научного коллектива. Такие устройства могут производить электроэнергию не только не причиняя вреда окружающей среде, но и напротив, очищая сточные воды. Результаты исследования представлены в журнале «Ученые записки Казанского университета».
В «живой батарейке» из микробов и растений электрический ток вырабатывается с помощью двух электродов. На одном (положительно заряженном аноде) возникает движение электронов, вызванное процессами в клетках растений и бактерий. На втором электроде (катоде) в то же время выделяется вода.
Растение и микробы становятся мини-электростанцией, работающей на естественных биохимических реакциях, рассказали в Тульском государственном университете (ТулГУ). Такие «батарейки» называют растительно-микробными топливными элементами (РМТЭ). В подобных устройствах чаще всего именно катодная реакция «тормозит» всю систему, что сказывается на ее эффективности, добавили ученые
Без вспомогательного вещества — катализатора — она протекает слишком медленно, а в современных РМТЭ в качестве ускорителя реакции используется дорогостоящая платина, что замедляет внедрение «зеленых батареек» в автономные системы очистки воды или их использование для поддержания работы маломощных датчиков и светодиодного освещения, рассказал заведующий лабораторией экологической и медицинской биотехнологии ТулГУ Сергей Алферов.
Коллектив ученых ТулГУ в партнерстве с коллегами из Иркутского национального исследовательского технического университета предложил более доступный материал для переработки кислорода в воду, одновременно в полтора раза увеличив мощность РМТЭ.
«»В нашей работе мы заменили платину более доступным диоксидом марганца. Этот материал показал высокую эффективность, улучшив характеристики растительного микробного топливного элемента. Со старым катализатором выходная мощность элемента составляла 20 мВт/м2, с новым — 33 мВт/м2 с одновременным уменьшением внутреннего сопротивления», — уточнили ученые.
Специалисты добавляют, что растительные микробные топливные элементы могут применяться на территориях с теплым климатом, где существует проблема с доступностью чистой воды. После лабораторных испытаний коллектив лаборатории сосредоточится на масштабировании получившейся системы и тестировании ее в условиях, приближенных к реальным.